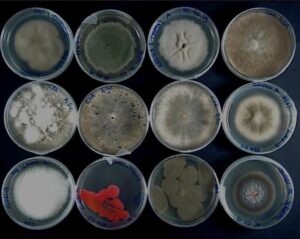

We would like to inform you about the opportunity to apply for the selection process for this international workshop, suitable for students, young researchers, or anyone working in the field of marine fungi research. The workshop has been organized as part of the PRIN 2022 project "Mycoseas", with Prof. Massimiliano Fenice as the scientific coordinator.





